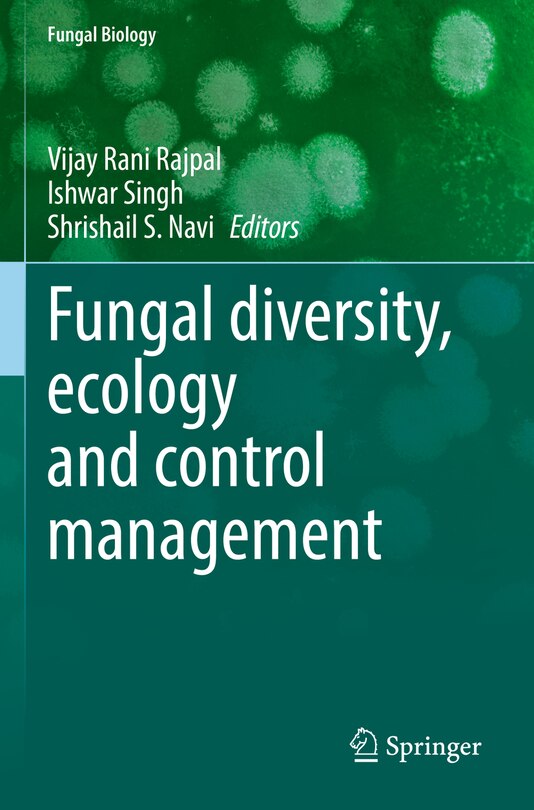

Free Preview of Fungal diversity, ecology and control management
$408.95
Online pricing. Prices and offers may vary in store.
Ship to me
Checking availability…
Buy now & pick up in store
Checking availability…
Find it in store
Checking availability…
Overview
Publisher: Springer Nature
Shipping dimensions: 9" H x 6" W x 1" L
ISBN: 9789811688799
Life stage: null